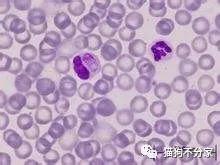
狗狗得了犬瘟怎么办？带你全面了解犬瘟病毒，铲屎官必看

狗瘟就是我们常说的犬瘟热,它的传染性极强,死亡率极高,基本狗狗染上后相当于判了死刑!所以狗爸狗妈们谈到犬瘟就谈瘟色变!今天pawbox泡泡盒就和大家谈谈犬瘟病毒!
犬瘟——亦称犬瘟热,属于病原性病毒。主要侵犯犬科、鼬科动物,比如雪貂和小浣熊,感染后潜伏期短,死亡率高达50%。
犬瘟病毒的生长环境
犬瘟病毒在高温常温或者干燥环境中只能存活几个小时,不过它在低温环境下(零上几度)、阴暗环境下能存活数周,在低温避光环境下甚至可以存活数年。
犬瘟病毒是个自来熟,传染性极强,通过空气就可以传播。所以如果你家多只狗狗,那么如果其中一只狗狗感染犬瘟,一定要及时隔离。它用过的东西,不要省钱, 一定要全部扔掉!
不过虽然犬瘟热病毒*伤杀**力很大,但是在感染狗狗之前是很怂的,日晒、高温以及各种各样的消毒水肥皂水一般都可以将病毒消灭,大家也不用太害怕。

感染犬瘟病毒会有哪些症状呢?
犬瘟病毒的临床症状有四种
1.卡他型
这是最常见的类型,症状有打喷嚏、咳嗽、厌食,有时轻度拉肚子。鼻分泌物呈脓性、淡黄绿色。病犬伴有呼吸困难,张口喘气的症状。
2.消化道型(胃肠型)
这种也比较常见,具体症状是口角流涎、呕吐、腹泻(水样、果酱样甚至血性,或有泡沫) ,脱水、消瘦、衰弱。口腔和舌溃疡。
3神经型
这是比较特殊的一类,内脏无明显变化, 一般出现于14天“康复”之后,突然出现症状。狗狗呈现有节律的持续痉挛,麻痹。随后后肢行路不稳、后腿不能站立,最后呼吸麻痹而死。
另一种神经型表现为癫痫样发作,出现痉挛,犬嚎叫。严重时,听、嗅、视觉全消失。病犬可以自我摧残,狂咬出现脓包的部位(奇痒),以至于露出骨头。不要犹豫,赶快送医院!

得了犬瘟怎么治?
用免疫血清并结合抗生素治疗。应用退热、镇静药及抗生素治疗。pawbox泡泡盒在这里不鼓励家庭救治,血清抗生素很难弄到,就算弄到也很难保存,就算保存好了,你也不好掌握剂量,等你都整明白了,也错过了最好的治疗时间!最好的方法就是及时送医。
预防是最好的治疗!
疫苗!疫苗!疫苗!
重要的事情说三遍!每年一定要定时接种疫苗!